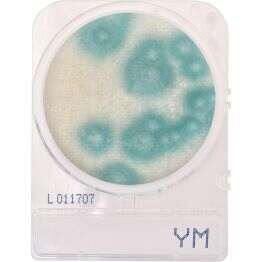

CompactDry™ Yeast/Mold (YM)
CompactDry™ is a ready-to-use system that reduces the time needed to perform microbial testing on food, cannabis, meat, cosmetics, raw materials, and more.
CompactDry™YM is a ready-to-use test method recommended for the determination of yeast and mold counts.
The benefits are easy to spot:
Each cassette comes with 4 connected plates that can be easily snapped apart to support a variety of dilution scenarios
- Sturdy frame, stackable packaging
- Self-diffusing media
- Ability to subculture without damage to colonies
- Stored at room temperature vs the competitor products with storage at temperatures less than or equal to 8°C
- No leakage
- Easy to label
Liên hệ mua hàng:
Công ty Labcare Việt Nam – chuyên cung cấp, phân phối Môi trường nuôi cấy vi sinh, test sinh hóa, kháng huyết thanh, hóa chất, dụng cụ, thiết bị, vật tư tiêu hao.
Hotline: 0938976508
Email: info@labcare.vn
Website: labcare.vn